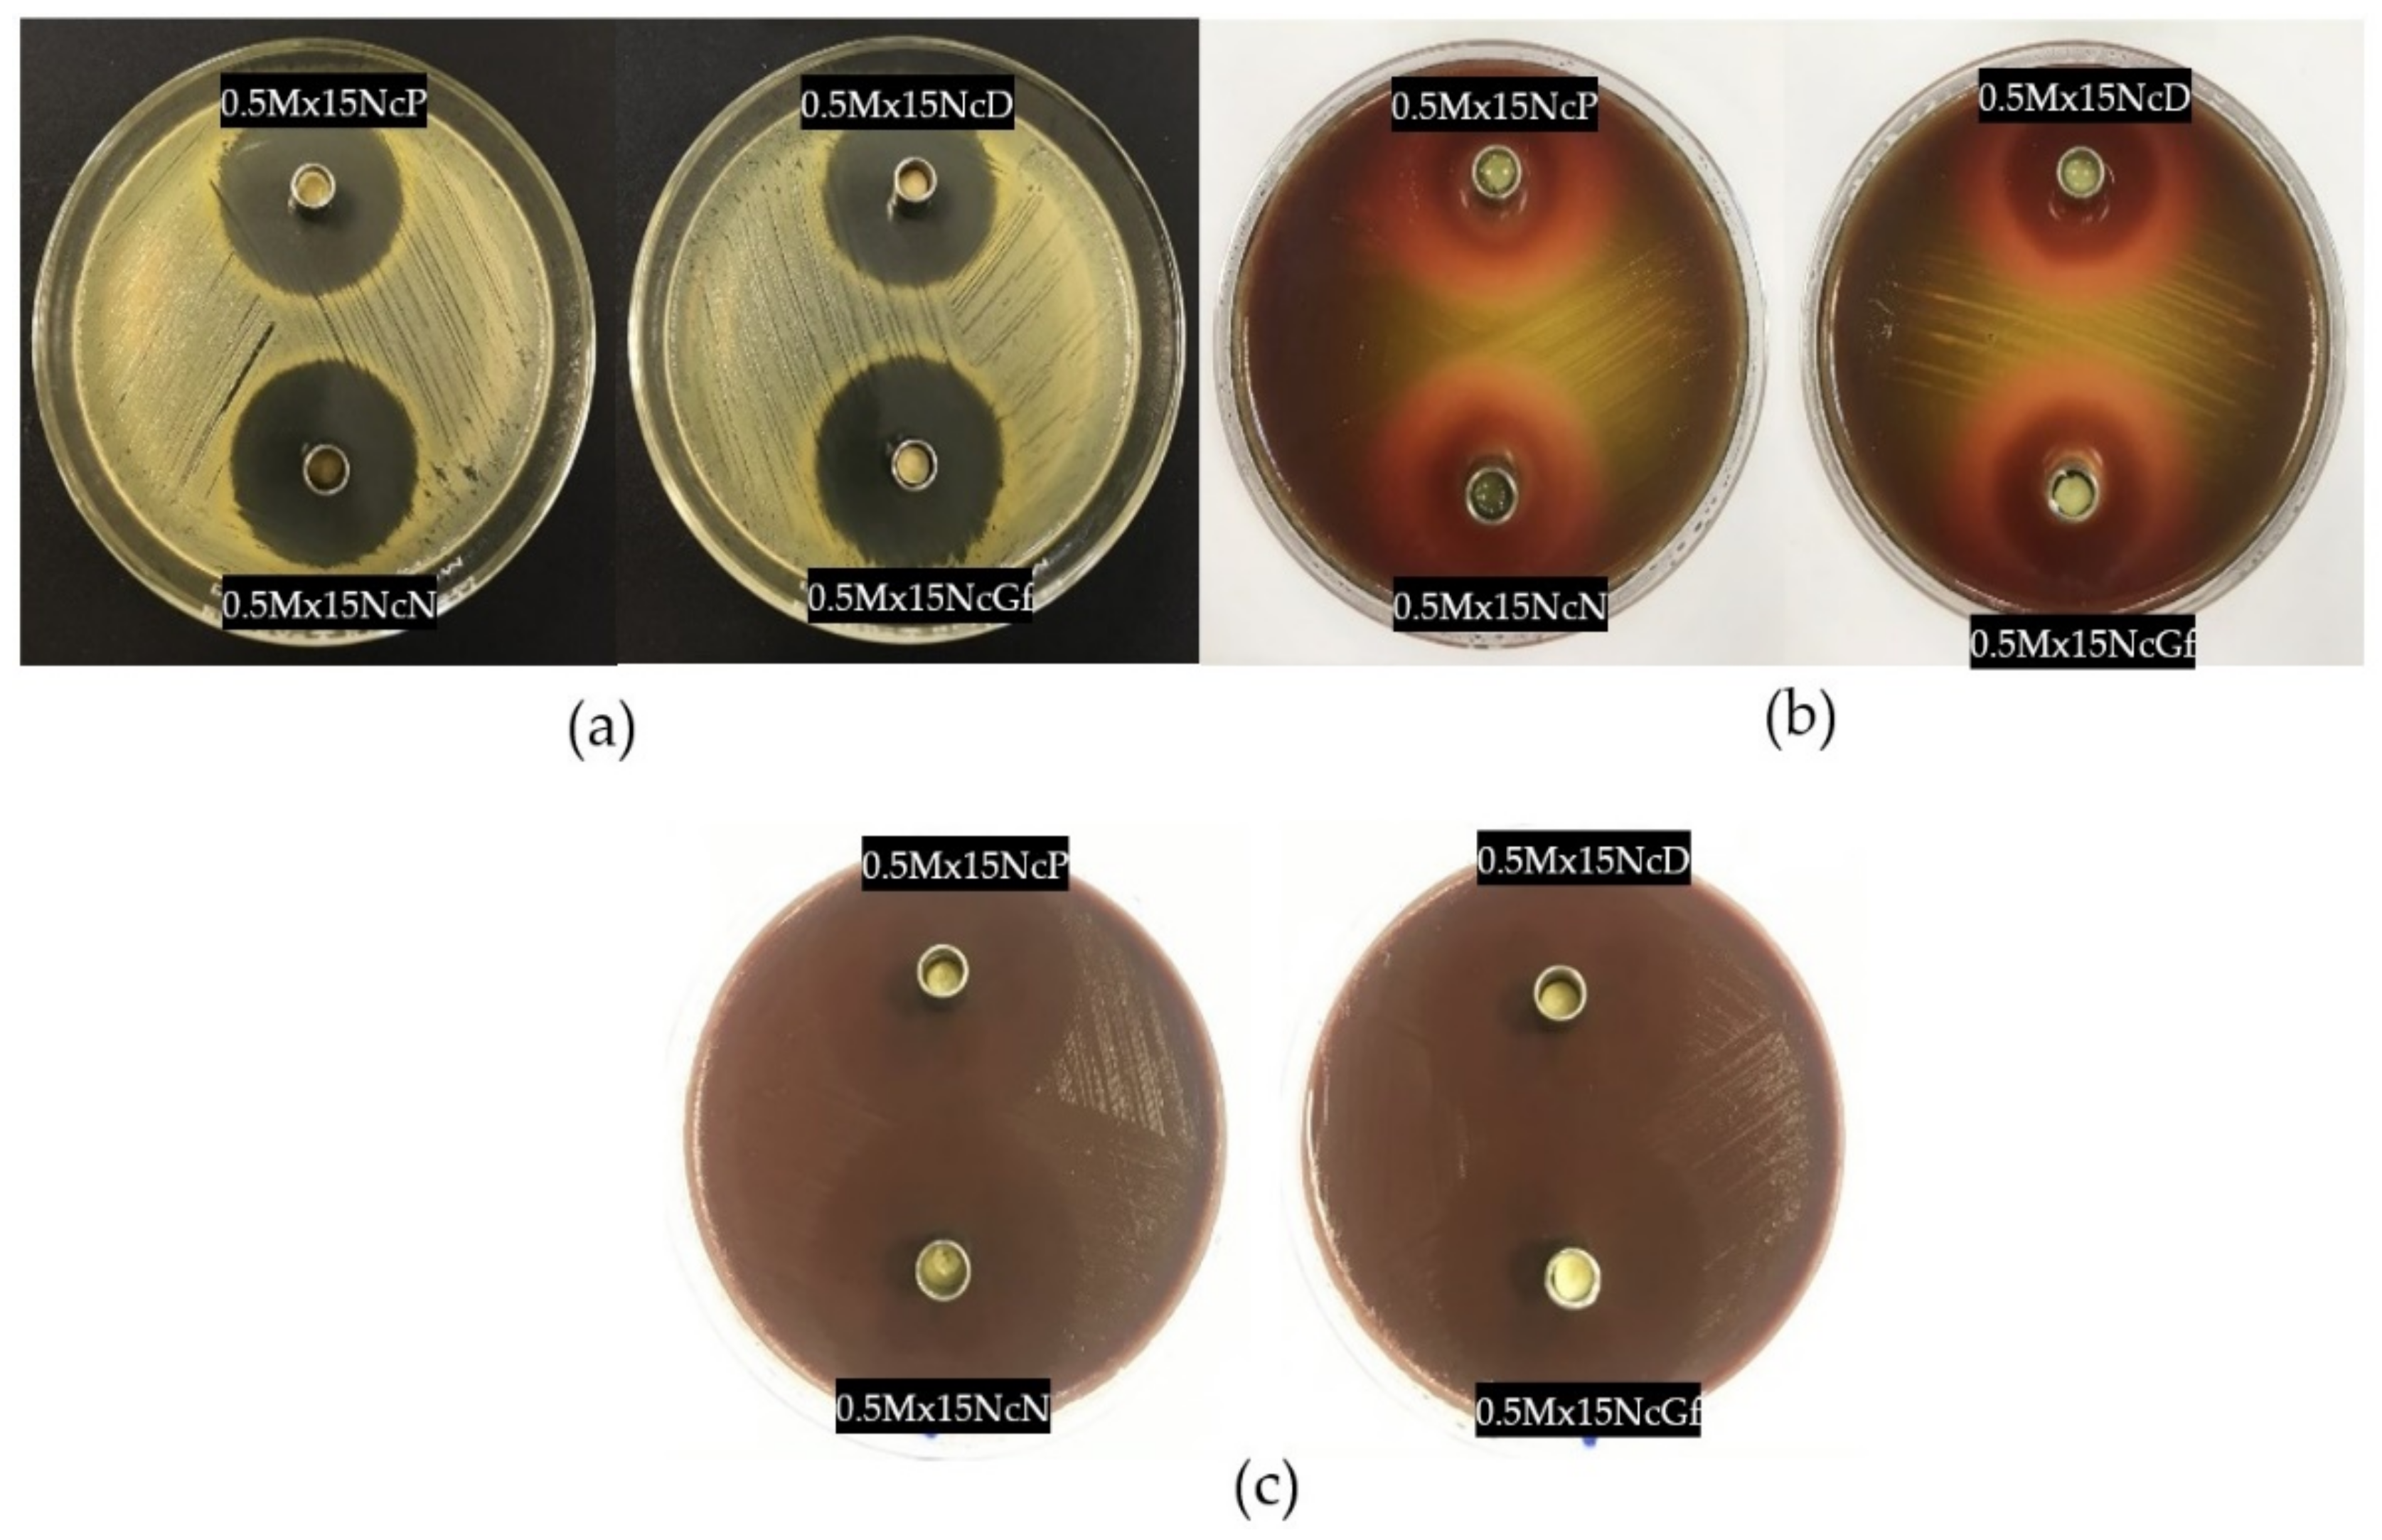
Gels 09 00572 g010

Moxifloxacin HCl-Incorporated Aqueous-Induced Nitrocellulose-Based In Situ Gel for Periodontal Pocket Delivery
Abstract
1. Introduction
2. Results and Discussion
2.1. Viscosity, Rheological Behavior, and Injectability
2.2. Water Tolerance
2.3. Gel Formation
2.4. In Vitro Drug Release Study
2.5. Scanning Electron Microscopy (SEM)
2.6. X-ray Tomographic Imaging
2.7. In Vitro Degradability
2.8. Antimicrobial Activities
3. Conclusions
4. Materials and Methods
4.1. Materials
4.2. Preparation of In Situ Forming Gel
4.3. Rheology and Viscosity Characterization
4.4. Injectability
4.5. Water Tolerance Test
4.6. Gel Formation Study
4.7. Drug Content and In Vitro Drug Release Studies
4.8. Scanning Electron Microscopy (SEM)
4.9. X-ray Imaging with X-ray Tomographic Microscopy
4.10. In Vitro Degradability
- = weight of the weighted sample in the cup at beginning;
- = weight of remaining sample at time n;
- = %Mx released at time n obtained from drug release study.
4.11. Antimicrobial Activities
4.12. Statistical Analysis
Author Contributions
Funding
Institutional Review Board Statement
Informed Consent Statement
Data Availability Statement
Acknowledgments
Conflicts of Interest
References
- Quinn, M.J. Chapter 11—Wildlife Toxicity Assessment for Nitrocellulose. In Wildlife Toxicity Assessments for Chemicals of Military Concern; Williams, M.A., Reddy, G., Quinn, M.J., Johnson, M.S., Eds.; Elsevier: Amsterdam, The Netherlands, 2015; pp. 217–226. [Google Scholar]
- DW Cellulosics. Walsroder® Nitrocellulose Essential for an Extra-Special Finish; DW Cellulosics: Bomlitz, Germany, 1998; p. 31. [Google Scholar]
- He, Y.; He, Y.; Liu, J.; Li, P.; Chen, M.; Wei, R.; Wang, J. Experimental study on the thermal decomposition and combustion characteristics of nitrocellulose with different alcohol humectants. J. Hazard. Mater. 2017, 340, 202–212. [Google Scholar] [CrossRef] [PubMed]
- Saunders, C.W.; Taylor, L.T. A review of the synthesis, chemistry and analysis of nitrocellulose. J. Energy Mater. 1990, 8, 149–203. [Google Scholar] [CrossRef]
- Liu, J. Nitrate Esters Chemistry and Technology; Springer: Singapore, 2019; pp. 469–476. [Google Scholar] [CrossRef]
- Samuel, J.; Edwards, P. Solvent-Based Inkjet Inks. In The Chemistry of Inkjet Inks; World Scientific: Singapore, 2009; pp. 141–159. [Google Scholar]
- Sun, S.; Feng, S.; Ji, C.; Shi, M.; He, X.; Xu, F.; Lu, T.J. Microstructural effects on permeability of Nitrocellulose membranes for biomedical applications. J. Membr. Sci. 2020, 595, 117502. [Google Scholar] [CrossRef]
- Fernández, J.G.; Almeida, C.A.; Fernández-Baldo, M.A.; Felici, E.; Raba, J.; Sanz, M.I. Development of nitrocellulose membrane filters impregnated with different biosynthesized silver nanoparticles applied to water purification. Talanta 2016, 146, 237–243. [Google Scholar] [CrossRef] [PubMed]
- Fridley, G.E.; Holstein, C.A.; Oza, S.B.; Yager, P. The evolution of nitrocellulose as a material for bioassays. MRS Bull. 2013, 38, 326–330. [Google Scholar] [CrossRef]
- Kim, B.B.; Im, W.J.; Byun, J.Y.; Kim, H.M.; Kim, M.-G.; Shin, Y.-B. Label-free CRP detection using optical biosensor with one-step immobilization of antibody on nitrocellulose membrane. Sens. Actuators B Chem. 2014, 190, 243–248. [Google Scholar] [CrossRef]
- Mu, X.; Yu, H.; Zhang, C.; Chen, X.; Cheng, Z.; Bai, R.; Wu, X.; Yu, Q.; Wu, C.; Diao, Y. Nano-porous nitrocellulose liquid bandage modulates cell and cytokine response and accelerates cutaneous wound healing in a mouse model. Carbohydr. Polym. 2016, 136, 618–629. [Google Scholar] [CrossRef]
- Khaing, E.M.; Intarapairot, T.; Santimaleeworagun, W.; Phorom, Y.; Chuenbarn, T.; Phaechamud, T. Natural-resin in-situ-forming gels: Physicochemical characteristics and bioactivities. Pharm. Sci. Asia 2021, 48, 461–470. [Google Scholar] [CrossRef]
- Srichan, T.; Phaechamud, T. Designing solvent exchange-induced in situ forming gel from aqueous insoluble polymers as matrix base for periodonttitis treatment. AAPS PharmSciTech 2017, 18, 194–201. [Google Scholar] [CrossRef]
- Khaing, E.M.; Mahadlek, J.; Okonogi, S.; Phaechamud, T. Lime peel oil-incorporated rosin-based antimicrobial in situ forming gel. Gels 2022, 8, 169. [Google Scholar] [CrossRef]
- Lertsuphotvanit, N.; Santimaleeworagun, W.; Narakornwit, W.; Chuenbarn, T.; Mahadlek, J.; Chantadee, T.; Phaechamud, T. Borneol-based antisolvent-induced in situ forming matrix for crevicular pocket delivery of vancomycin hydrochloride. Int. J. Pharm. 2022, 617, 121603. [Google Scholar] [CrossRef]
- Senarat, S.; Wai, L.W.; Mahadlek, J.; Phaechamud, T. Doxycycline hyclate-loaded in situ forming gels composed from bleached shellac, Ethocel, and Eudragit RS for periodontal pocket delivery. Saudi Pharm. J. 2021, 29, 252–263. [Google Scholar] [CrossRef]
- Madan, M.; Bajaj, A.; Lewis, S.; Udupa, N.; Baig, J.A. In situ forming polymeric drug delivery systems. Indian J. Pharm. Sci. 2009, 71, 242–251. [Google Scholar] [CrossRef]
- Khairy, G.M.; Abd El-Naby, Z.A.; Elgindy, A.M.A.; Duerkop, A.; Abdel Hameed, E.A. Sensitive Determination of Moxifloxacin HCl in Pharmaceuticals or Human Plasma Using Luminescence or Eye Vision. Chemosensors 2022, 10, 378. [Google Scholar] [CrossRef]
- Mah, F.S. Fourth-generation fluoroquinolones: New topical agents in the war on ocular bacterial infections. Curr. Opin. Ophthalmol. 2004, 15, 316–320. [Google Scholar] [CrossRef]
- Swain, G.P.; Patel, S.; Gandhi, J.; Shah, P. Development of Moxifloxacin Hydrochloride loaded in-situ gel for the treatment of periodontitis: In-vitro drug release study and antibacterial activity. J. Oral Biol. Craniofac. Res. 2019, 9, 190–200. [Google Scholar] [CrossRef]
- Guo, Q.; Aly, A.; Schein, O.; Trexler, M.M.; Elisseeff, J.H. Moxifloxacin in situ gelling microparticles-bioadhesive delivery system. Results Pharma Sci. 2012, 2, 66–71. [Google Scholar] [CrossRef]
- Zafar, A.; Alsaidan, O.A.; Imam, S.S.; Yasir, M.; Alharbi, K.S.; Khalid, M. Formulation and Evaluation of Moxifloxacin Loaded Bilosomes In-Situ Gel: Optimization to Antibacterial Evaluation. Gels 2022, 8, 418. [Google Scholar] [CrossRef]
- Cardoso, C.O.; Ferreira-Nunes, R.; Cunha-Filho, M.; Gratieri, T.; Gelfuso, G.M. In situ gelling microemulsion for topical ocular delivery of moxifloxacin and betamethasone. J. Mol. Liq. 2022, 360, 119559. [Google Scholar] [CrossRef]
- Mandal, S.; Thimmasetty, M.K.; Prabhushankar, G.; Geetha, M. Formulation and evaluation of an In Situ gel-forming ophthalmic formulation of moxifloxacin hydrochloride. Int. J. Pharm. Investig. 2012, 2, 78–82. [Google Scholar] [CrossRef]
- Borude, A.D.; Mahale, N.B. Formulation and evaluation of dental implant moxifloxaxin HCl for the treatment of periodontitis. Int. J. Pharm. Biol. Sci. 2013, 3, 49–55. [Google Scholar]
- Thakur, R.R.S.; McMillan, H.L.; Jones, D.S. Solvent induced phase inversion-based in situ forming controlled release drug delivery implants. J. Control. Release 2014, 176, 8–23. [Google Scholar] [CrossRef] [PubMed]
- Jouyban, A.; Fakhree, M.A.; Shayanfar, A. Review of pharmaceutical applications of N-methyl-2-pyrrolidone. J. Pharm. Pharm. Sci. 2010, 13, 524–535. [Google Scholar] [CrossRef] [PubMed]
- Agrawal, A.G.; Kumar, A.; Gide, P.S. Toxicity study of a self-nanoemulsifying drug delivery system containing N-methyl pyrrolidone. Drug Res. 2015, 65, 446–448. [Google Scholar] [CrossRef] [PubMed]
- Shortt, J.; Hsu, A.K.; Martin, B.P.; Doggett, K.; Matthews, G.M.; Doyle, M.A.; Ellul, J.; Jockel, T.E.; Andrews, D.M.; Hogg, S.J.; et al. The Drug Vehicle and Solvent N-Methylpyrrolidone Is an Immunomodulator and Antimyeloma Compound. Cell Reports 2014, 7, 1009–1019. [Google Scholar] [CrossRef] [PubMed]
- Mehtälä, P.; Pashley, D.H.; Tjäderhane, L. Effect of dimethyl sulfoxide on dentin collagen. Dent. Mater. J. 2017, 33, 915–922. [Google Scholar] [CrossRef]
- Yu, Z.W.; Quinn, P.J. Dimethyl sulphoxide: A review of its applications in cell biology. Biosci. Rep. 1994, 14, 259–281. [Google Scholar] [CrossRef]
- Chantadee, T.; Sawangsri, P.; Santimaleeworagun, W.; Phaechamud, T. Vancomycin hydrochloride-loaded stearic acid/lauric acid in situ forming matrix for antimicrobial inhibition in patients with joint infection after total knee arthroplasty. Mater. Sci. Eng. C 2020, 115, 110761. [Google Scholar] [CrossRef]
- Chantadee, T.; Santimaleeworagun, W.; Phorom, Y.; Chuenbarn, T.; Phaechamud, T. Vancomycin HCl-loaded lauric acid in situ-forming gel with phase inversion for periodontitis treatment. J. Drug Deliv. Sci. Technol. 2020, 57, 101615. [Google Scholar] [CrossRef]
- Ahmed, T. Review: Approaches to develop PLGA based in situ gelling system with low initial burst. Pak. J. Pharm. Sci. 2015, 28, 657–665. [Google Scholar]
- Lewis, R.J. Sax’s Dangerous Properties of Industrial Materials, 9th ed.; Van Nostrand Reinhold: New York, NY, USA, 1996; Volume 1–3, 2844p. [Google Scholar]
- Agostini, E.; Winter, G.; Engert, J. Water-based preparation of spider silk films as drug delivery matrices. J. Control. Release 2015, 213, 134–141. [Google Scholar] [CrossRef]
- Kranz, H.; Bodmeier, R. A novel in situ forming drug delivery system for controlled parenteral drug delivery. Int. J. Pharm. 2007, 332, 107–114. [Google Scholar] [CrossRef]
- Cao, X.; Geng, J.; Su, S.; Zhang, L.; Xu, Q.; Zhang, L.; Xie, Y.; Wu, S.; Sun, Y.; Gao, Z. Doxorubicin-loaded zein in situ gel for interstitial chemotherapy. Chem. Pharm. Bull. 2012, 60, 1227–1233. [Google Scholar] [CrossRef]
- Gao, Z.; Ding, P.; Zhang, L.; Shi, J.; Yuan, S.; Wei, J.; Chen, D. Study of a pingyangmycin delivery system: Zein/Zein-SAIB in situ gels. Int. J. Pharm. 2007, 328, 57–64. [Google Scholar] [CrossRef]
- Gad, H.A.; El-Nabarawi, M.A.; Abd El-Hady, S.S. Formulation and Evaluation of PLA and PLGA In Situ Implants Containing Secnidazole and/or Doxycycline for Treatment of Periodontitis. AAPS PharmSciTech 2008, 9, 878. [Google Scholar] [CrossRef]
- Phaechamud, T.; Praphanwittaya, P.; Laotaweesub, K. Solvent effect on fluid characteristics of doxycycline hyclate-loaded bleached shellac in situ-forming gel and -microparticle formulations. J. Pharm. Investig. 2018, 48, 409–419. [Google Scholar] [CrossRef]
- Zhang, Q.; Fassihi, M.A.; Fassihi, R. Delivery considerations of highly viscous polymeric fluids mimicking concentrated biopharmaceuticals: Assessment of injectability via measurement of total work done “WT.”. AAPS PharmSciTech 2018, 19, 1520–1528. [Google Scholar] [CrossRef]
- Rungseevijitprapa, W.; Bodmeier, R. Injectability of biodegradable in situ forming microparticle systems (ISM). Eur. J. Pharm. Sci. 2009, 36, 524–531. [Google Scholar] [CrossRef]
- Senarat, S.; Rojviriya, C.; Puyathorn, N.; Lertsuphotvanit, N.; Phaechamud, T. Levofloxacin HCl-Incorporated Zein-Based Solvent Removal Phase Inversion In Situ Forming Gel for Periodontitis Treatment. Pharmaceutics 2023, 15, 1199. [Google Scholar] [CrossRef]
- Senarat, S.; Charoenteeraboon, J.; Praphanwittaya, P.; Phaechamud, T. Phase behavior of doxycycline hyclate-incorporated bleached shellac in-situ forming gel/microparticle after solvent movement. Key Eng. Mater. 2020, 859, 21–26. [Google Scholar] [CrossRef]
- Puyathorn, N.; Senarat, S.; Lertsuphotvanit, N.; Phaechamud, T. Physicochemical and Bioactivity Characteristics of Doxycycline Hyclate-Loaded Solvent Removal-Induced Ibuprofen-Based In Situ Forming Gel. Gels 2023, 9, 128. [Google Scholar] [CrossRef] [PubMed]
- Philippot, P.; Lenoir, N.; D’Hoore, W.; Bercy, P. Improving patients’ compliance with the treatment of periodontitis: A controlled study of behavioural intervention. J. Clin. Periodontol. 2005, 32, 653–658. [Google Scholar] [CrossRef] [PubMed]
- Lwin, W.W.; Puyathorn, N.; Senarat, S.; Mahadlek, J.; Phaechamud, T. Emerging role of polyethylene glycol on doxycycline hyclate-incorporated Eudragit RS in situ forming gel for periodontitis treatment. J. Pharm. Investig. 2020, 50, 81–94. [Google Scholar] [CrossRef]
- Khiang, E.M.; Intaraphairot, T.; Chuenbarn, T.; Chantadee, T.; Phaechamud, T. Natural resin-based solvent exchange induced in-situ forming gel for vancomycin HCl delivery to periodontal pocket. Mater. Today Proc. 2021, 47, 3585–3593. [Google Scholar] [CrossRef]
- Parent, M.; Nouvel, C.; Koerber, M.; Sapin, A.; Maincent, P.; Boudier, A. PLGA in situ implants formed by phase inversion: Critical physicochemical parameters to modulate drug release. J. Control. Release 2013, 172, 292–304. [Google Scholar] [CrossRef]
- Ibrahim, T.M.; El-Megrab, H.; El nahas, H. An overview of PLGA in-situ forming implants based on solvent exchange technique: Effect of formulation components and characterization. Pharm. Dev. Technol. 2021, 26, 1–20. [Google Scholar] [CrossRef]
- Withers, P.; Bouman, C.; Carmignato, S.; Cnudde, V.; Grimaldi, D.; Hagen, C.K.; Maire, E.; Manley, M.; Du Plessis, A.; Stock, S. X-ray computed tomography. Nat. Rev. Methods Primers 2021, 1, 18. [Google Scholar] [CrossRef]
- He, T. Finger-Like Structure. In Encyclopedia of Membranes; Drioli, E., Giorno, L., Eds.; Springer: Berlin/Heidelberg, Germany, 2015. [Google Scholar] [CrossRef]
- Xiao, P.; Nghiem, L.D.; Yin, Y.; Li, X.-M.; Zhang, M.; Chen, G.; Song, J.; He, T. A sacrificial-layer approach to fabricate polysulfone support for forward osmosis thin-film composite membranes with reduced internal concentration polarisation. J. Membr. Sci. 2015, 481, 106–114. [Google Scholar] [CrossRef]
- Hadavi, E.; de Vries, R.H.W.; Smink, A.M.; de Haan, B.; Leijten, J.; Schwab, L.W.; Karperien, M.H.; de Vos, P.; Dijkstra, P.J.; van Apeldoorn, A.A. In vitro degradation profiles and in vivo biomaterial-tissue interactions of microwell array delivery devices. J. Biomed. Mater. Res. B Appl. Biomater. 2021, 109, 117–127. [Google Scholar] [CrossRef]
- Senarat, S.; Pichayakorn, W.; Phaechamud, T.; Tuntarawongsa, S. Antisolvent Eudragit® polymers based in situ forming gel for periodontal controlled drug delivery. J. Drug Deliv. Sci. Technol. 2023, 82, 104361. [Google Scholar] [CrossRef]
- Souto, R.; Andrade, A.F.B.D.; Uzeda, M.; Colombo, A.P.V. Prevalence of non-oral pathogenic bacteria in subgingival biofilm of subjects with chronic periodontits. Braz. J. Microbiol. 2006, 37, 208–215. [Google Scholar] [CrossRef]
- Carpentier, B.; Cerf, O. Biofilms and their consequences with particular reference to hygiene in the food industry. J. Appl. Bacteriol. 1993, 75, 499–511. [Google Scholar] [CrossRef]
- Costerton, J.W.; Lewandowski, Z.; Caldwell, D.E.; Korber, D.R.; Lappin-Scott, H.M. Microbial biofilms. Annu. Rev. Microbiol. 1995, 49, 711–745. [Google Scholar] [CrossRef]
- Rein, S.M.; Intaraphairot, T.; Santimaleeworagun, W.; Chantadee, T.; Chuenbarn, T.; Phaechamud, T. Fluid properties of solvents and oils used in in situ forming microparticles. Thai J. Pharm. Sci. 2022, 46, 46–55. [Google Scholar]
- Barakat, N.S. Evaluation of glycofurol-based gel as a new vehicle for topical application of Naproxen. AAPS PharmSciTech 2010, 111, 1138–1146. [Google Scholar] [CrossRef]
- Lee, Y.; Gou, Y.; Pan, X.; Gu, Z.; Xie, H. Advances of multifunctional hydrogels for periodontal disease. Smart Mater. Med. 2023, 4, 460–467. [Google Scholar] [CrossRef]
- Ding, Y.; Wang, Y.; Li, J.; Tang, M.; Chen, H.; Wang, G.; Guo, J.; Gui, S. Microemulsion-thermosensitive gel composites as in situ-forming drug reservoir for periodontitis tissue repair through alveolar bone and collagen regeneration strategy. Pharm. Dev. Technol. 2023, 28, 30–39. [Google Scholar] [CrossRef]
- Pardeshi, S.R.; Mistari, H.A.; Jain, R.S.; Pardeshi, P.R.; Rajput, R.L.; Mahajan, D.S.; Shirsath, N.R. Development and optimization of sustained release moxifloxacin hydrochloride loaded nanoemulsion for ophthalmic drug delivery: A 32 factorial design approach. Micro Nanosyst. 2021, 13, 292–302. [Google Scholar] [CrossRef]
- Sun, N.; Yao, X.; Liu, J.; Li, J.; Yang, N.; Zhao, G.; Dai, C. Breakup and coalescence mechanism of high-stability bubbles reinforced by dispersed particle gel particles in the pore-throat micromodel. Geoenergy Sci. Eng. 2023, 223, 211513. [Google Scholar] [CrossRef]
- Esfahani, S.; Akbari, J.; Soleimani-Amiri, S.; Mirzaei, M.; Gol, A.G. Assessing the drug delivery of ibuprofen by the assistance of metal-doped graphenes: Insights from density functional theory. Diam. Relat. Mater. 2023, 135, 109893. [Google Scholar] [CrossRef]
- Da’i, M.; Wikantyasning, E.R.; Maryati; Wahyuni, A.S.; Mirzaei, M. A Titanium-Enhanced Boron Nitride Fullerene for the Drug Delivery of 5-Fluorouracil Anticancer: DFT Study. Biointerface Res. Appl. Chem. 2023, 13, 434. [Google Scholar] [CrossRef]
- Saadh, M.J.; Abdullaev, S.S.; Falcon-Roque, J.M.; Cosme-Pecho, R.D.; Castillo-Acobo, R.Y.; Obaid, M.; Mohany, M.; Al-Rejaie, S.S.; Mirzaei, M.; Da’, M.; et al. Sensing functions of oxidized forms of carbon, silicon, and silicon-carbon nanocages towards the amantadine drug: DFT assessments. Diam. Relat. Mater. 2023, 137, 110137. [Google Scholar] [CrossRef]
- He, S.; Wu, L.; Li, X.; Sun, H.; Xiong, T.; Liu, J.; Huang, C.; Xu, H.; Sun, H.; Chen, W.; et al. Metal-organic frameworks for advanced drug delivery. Acta Pharm. Sin. B 2021, 11, 2362–2395. [Google Scholar] [CrossRef] [PubMed]
- Mittal, A.; Roy, I.; Gandhi, S. Drug Delivery Applications of Metal-Organic Frameworks (MOFs). In Drug Carriers; IntechOpen: London, UK, 2022. [Google Scholar] [CrossRef]
- Jeyaseelan, C.; Jain, P.; Soin, D.; Gupta, D. Metal organic frameworks: An effective application in drug delivery systems. Inorg. Nano-Met. Chem. 2022, 52, 1463–1475. [Google Scholar] [CrossRef]

| Formula | Zero Order | First Order | Higuchi’s | Korsmeyer–Peppas | ||
|---|---|---|---|---|---|---|
| r2 | r2 | r2 | r2 | n | Release Mechanism | |
| 0.5Mx15NcD | 0.6475 | 0.4541 | 0.8074 | 0.9155 | 0.298 ± 0.057 | Fickian diffusion |
| 0.5Mx15NcGf | 0.7150 | 0.6826 | 0.8765 | 0.7805 | 0.278 ± 0.012 | Fickian diffusion |
| 0.5Mx15NcPy | 0.9086 | 0.8892 | 0.9786 | 0.9705 | 0.458 ± 0.047 | Fickian diffusion |
| 0.5Mx15NcN | 0.5725 | 0.3375 | 0.7547 | 0.8492 | 0.247 ± 0.053 | Fickian diffusion |
| Day | % Obtained Remaining Weight (%wobt) | % Experimental Remaining Weight (%wex) | ||||||
|---|---|---|---|---|---|---|---|---|
| 0.5Mx15NcD | 0.5Mx15NcGf | 0.5Mx15NcPy | 0.5Mx15NcN | 0.5Mx15NcD | 0.5Mx15NcGf | 0.5Mx15NcPy | 0.5Mx15NcN | |
| 1 | 14.2 | 21.7 | 26.9 | 17.5 | 21.6 | 27.2 | 33.7 | 28.7 |
| 3 | 13.6 | 18.2 | 17.6 | 16.8 | 15.2 | 23.4 | 29.2 | 22.4 |
| 5 | 13.8 | 16.3 * | 17.0 | 15.4 | 13.4 | 20.5 | 25.1 | 20.7 |
| 7 | 12.5 | 14.6 * | 16.2 | 15.2 | 13.1 | 19.6 | 22.6 | 20.9 |
| Formula | Inhibition Zone ± S.D. (mm) | |||||
|---|---|---|---|---|---|---|
| S. aureus 6538 | S. aureus 43,300 (MRSA) | S. aureus 6532 | S. aureus 25,923 | P. gingivalis ATCC 33,277 | A. actinomycetemcomitans ATCC 29,522 | |
| NMP | 15.0 ± 0.8 | 15.7 ± 0.5 | 14.0 ± 0.8 | 13.7 ± 0.5 | 15.7 ± 0.5 | 42.0 ± 1.6 |
| 2-PYR | 17.7 ± 0.5 | 18.7 ± 0.9 | 16.7 ± 1.2 | 15.7 ± 0.5 | 20.7 ± 0.9 | 42.3 ± 0.5 |
| DMSO | 11.3 ± 0.5 | 12.0 ± 0.0 | 10.0 ± 0.8 | 9.7 ± 0.5 | 17.3 ± 0.5 | 26.3 ± 0.9 |
| Glycerol formal | 11.3 ± 0.5 | 11.3 ± 0.5 | 11.0 ± 0.8 | 13.3 ± 0.5 | 16.0 ± 0.8 | 32.0 ± 0.8 |
| 15NcN | 11.3 ± 0.5 * | 13.7 ± 1.2 | 14.0 ± 1.6 | 11.7 ± 1.2 | 12.0 ± 0.8 | 34.7 ± 0.9 * |
| 15NcPy | 12.0 ± 0.8 * | 15.7 ± 1.2 * | 13.7 ± 1.2 | 12.7 ± 0.5 * | 13.7 ± 1.7 * | 34.7 ± 1.2 * |
| 15NcD | 9.7 ± 0.5 | 10.0 ± 0.8 | 10.3 ± 0.5 | - * | 14.3 ± 1.2 | 21.3 ± 0.5 * |
| 15NcGf | - * | 12.0 ± 0.8 | 12.7 ± 1.2 | 10.0 ± 0.0 | 15.0 ± 0.8 | 29.7 ± 1.2 * |
| 0.5MxN | 32.0 ± 0.8 | 31.3 ± 0.5 | 33.0 ± 0.8 | 30.3 ± 0.5 | 29.0 ± 2.4 | 44.3 ± 0.5 |
| 0.5MxP | 33.3 ± 0.5 | 32.3 ± 0.5 | 33.3 ± 0.9 | 32.7 ± 0.5 | 25.7 ± 0.9 | 45.0 ± 0.8 |
| 0.5MxG | 37.7 ± 1.2 | 37.0 ± 0.8 | 38.0 ± 0.8 | 35.3 ± 0.5 | 34.7 ± 0.5 | 45.0 ± 0.8 |
| 0.5MxD | 37.7 ± 0.5 | 37.7 ± 0.5 | 37.7 ± 0.9 | 35.3 ± 0.9 | 32.7 ± 0.9 | 45.7 ± 0.9 |
| 0.5Mx15NcN | 28.7 ± 0.5 ** | 29.7 ± 1.2 | 30.0 ± 1.6 | 27.0 ± 0.8 ** | 25.7 ± 0.9 | 39.7 ± 0.5 ** |
| 0.5Mx15NcPy | 26.7 ± 0.5 ** | 28.3 ± 0.5 ** | 28.0 ± 0.8 ** | 27.0 ± 0.0 ** | 27.0 ± 0.8 | 40.7 ± 0.5 ** |
| 0.5Mx15NcGf | 32.7 ± 0.5 ** | 31.0 ± 0.0 ** | 32.7 ± 0.5 | 30.0 ± 0.0 ** | 26.7 ± 0.5 ** | 41.0 ± 0.8 |
| 0.5Mx15NcD | 33.7 ± 0.5 ** | 31.7 ± 0.5 ** | 34.0 ± 0.8 ** | 29.3 ± 1.2 ** | 27.3 ± 0.9 ** | 43.3 ± 0.5 ** |
| Formula | Moxifloxacin HCl (Mx) | Nitrocellulose (N) | NMP | Py | DMSO | Gf |
|---|---|---|---|---|---|---|
| (% w/w) | (% w/w) | (% w/w) | (% w/w) | (% w/w) | (% w/w) | |
| 15NcN | - | 15 | 85 | - | - | - |
| 15NcPy | - | 15 | - | 85 | - | - |
| 15NcD | - | 15 | - | - | 85 | - |
| 15NcGf | - | 15 | - | - | - | 85 |
| 0.5MxN | 0.5 | - | 99.5 | - | - | - |
| 0.5MxPy | 0.5 | - | - | 99.5 | - | - |
| 0.5MxGf | 0.5 | - | - | - | 99.5 | - |
| 0.5MxD | 0.5 | - | - | - | - | 99.5 |
| 0.5Mx15NcN | 0.5 | 15 | 84.5 | - | - | - |
| 0.5Mx15NcPy | 0.5 | 15 | - | 84.5 | - | - |
| 0.5Mx15NcGf | 0.5 | 15 | - | - | 84.5 | - |
| 0.5Mx15NcD | 0.5 | 15 | - | - | - | 84.5 |
Disclaimer/Publisher’s Note: The statements, opinions and data contained in all publications are solely those of the individual author(s) and contributor(s) and not of MDPI and/or the editor(s). MDPI and/or the editor(s) disclaim responsibility for any injury to people or property resulting from any ideas, methods, instructions or products referred to in the content. |
© 2023 by the authors. Licensee MDPI, Basel, Switzerland. This article is an open access article distributed under the terms and conditions of the Creative Commons Attribution (CC BY) license (https://creativecommons.org/licenses/by/4.0/).
Share and Cite
Senarat, S.; Rojviriya, C.; Sarunyakasitrin, K.; Charoentreeraboon, J.; Pichayakorn, W.; Phaechamud, T. Moxifloxacin HCl-Incorporated Aqueous-Induced Nitrocellulose-Based In Situ Gel for Periodontal Pocket Delivery. Gels 2023, 9, 572. https://doi.org/10.3390/gels9070572
Senarat S, Rojviriya C, Sarunyakasitrin K, Charoentreeraboon J, Pichayakorn W, Phaechamud T. Moxifloxacin HCl-Incorporated Aqueous-Induced Nitrocellulose-Based In Situ Gel for Periodontal Pocket Delivery. Gels. 2023; 9(7):572. https://doi.org/10.3390/gels9070572
Chicago/Turabian StyleSenarat, Setthapong, Catleya Rojviriya, Katekeaw Sarunyakasitrin, Juree Charoentreeraboon, Wiwat Pichayakorn, and Thawatchai Phaechamud. 2023. "Moxifloxacin HCl-Incorporated Aqueous-Induced Nitrocellulose-Based In Situ Gel for Periodontal Pocket Delivery" Gels 9, no. 7: 572. https://doi.org/10.3390/gels9070572
APA StyleSenarat, S., Rojviriya, C., Sarunyakasitrin, K., Charoentreeraboon, J., Pichayakorn, W., & Phaechamud, T. (2023). Moxifloxacin HCl-Incorporated Aqueous-Induced Nitrocellulose-Based In Situ Gel for Periodontal Pocket Delivery. Gels, 9(7), 572. https://doi.org/10.3390/gels9070572

